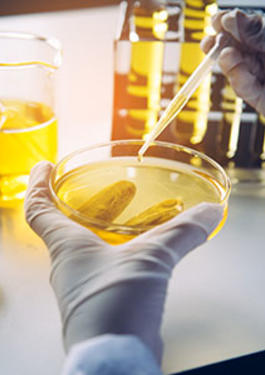
Fuel Oil Testing

Oil & Petrochemicals
Inspectorate is a core part of the Bureau Veritas Commodities Division. With origins dating back over 150 years, Inspectorate has an outstanding reputation for independence and technical excellence within the oil, gas and petrochemical industries.
Inspectorate provides world class service and support at every major loading, discharge and STS location. With a comprehensive network of qualified inspectors and state-of-the-art laboratories, we are able to provide reliable quality and quantity determination, along with the local and global industry knowledge that is required to promote successful trade.
We consider every customer’s unique business profile and can provide customized service solutions best suited to meet individual and corporate requirements. Ethical compliance, Health and Safety, and Environmental conservation are on top of our agenda and our emphasis on adherence to these have helped in our journey to become a leading player in the field of Oil & Petroleum inspections . We are fully committed to continuing our adherence to industry and other applicable internal and external standards, and have internal teams dedicated to function in all global regions.
Our core services include: